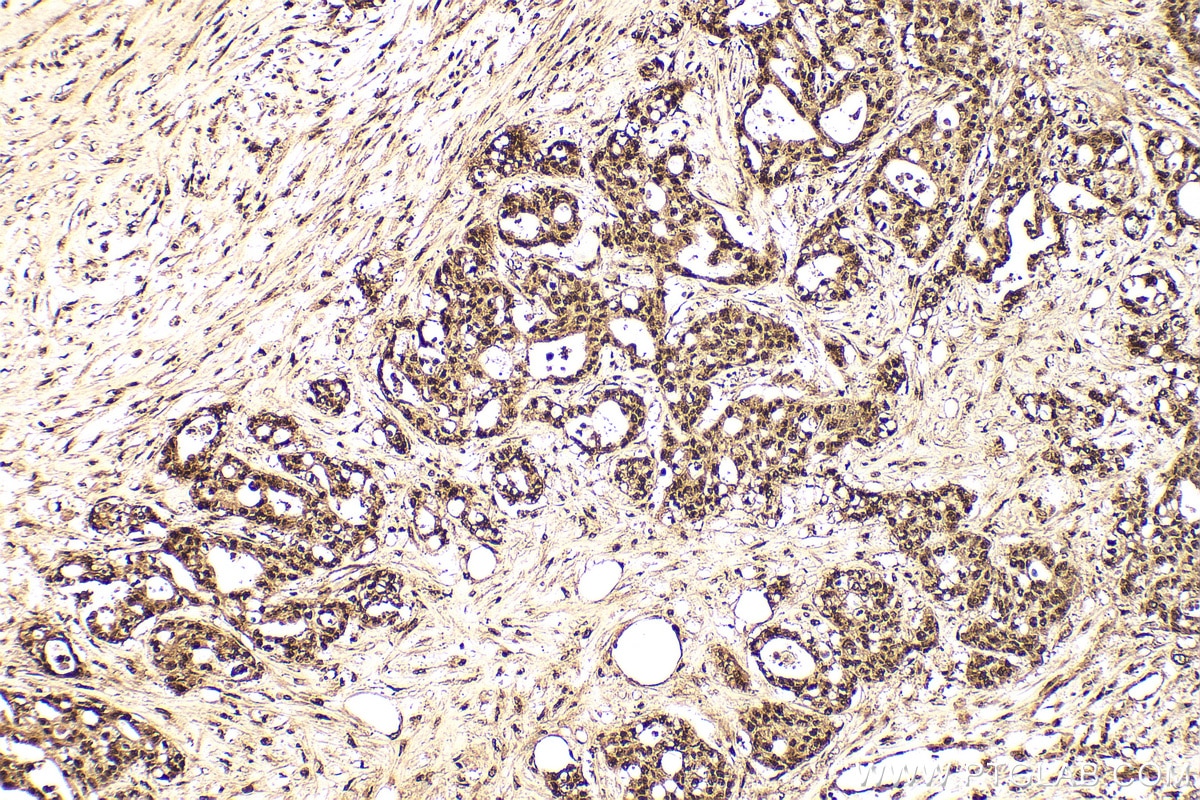
Immunohistochemistry (IHC) staining of human colon cancer tissue using HDGF Polyclonal antibody (11344-1-AP)
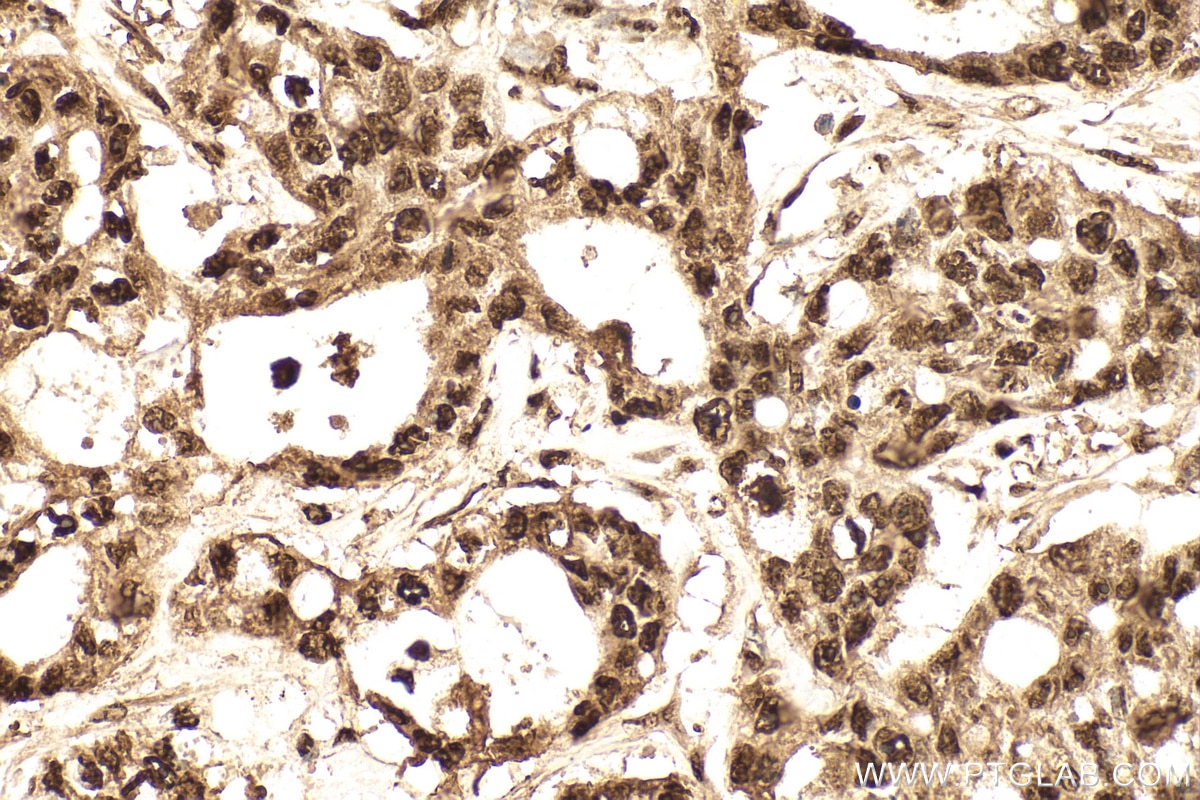
Immunohistochemistry (IHC) staining of human colon cancer tissue using HDGF Polyclonal antibody (11344-1-AP)
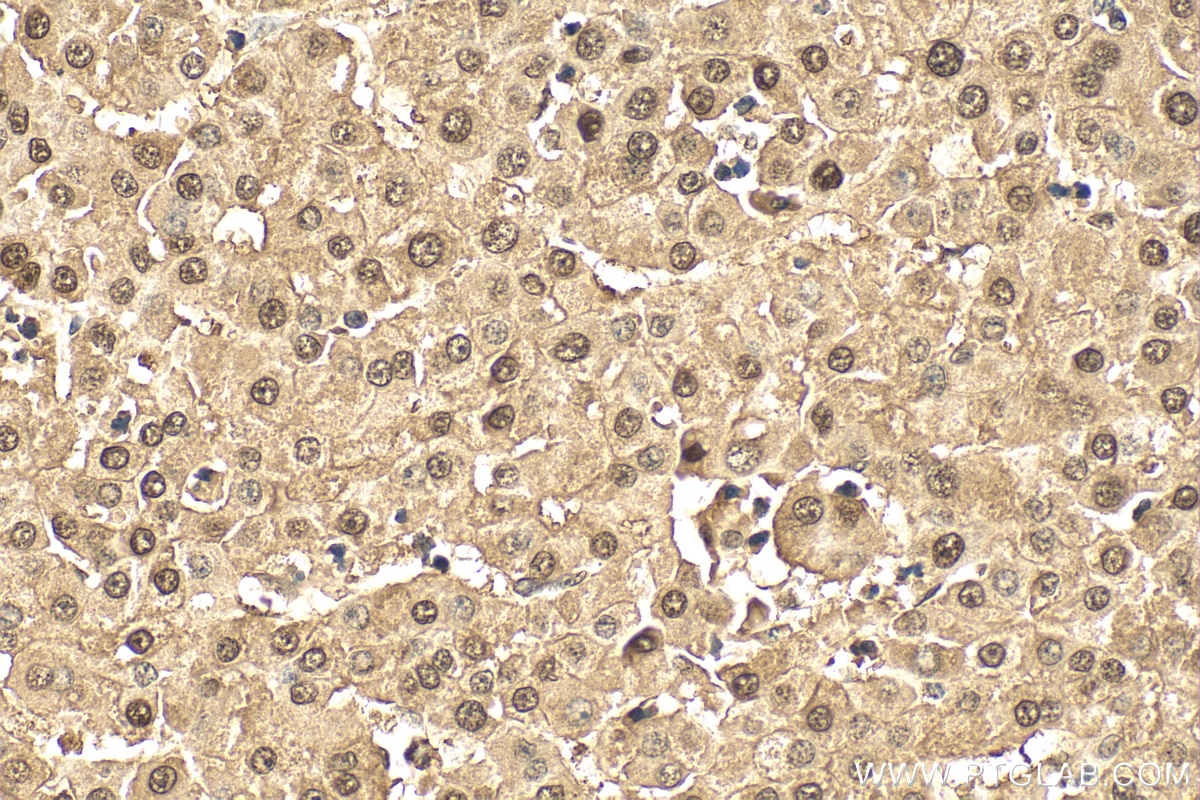
Immunohistochemistry (IHC) staining of human liver cancer tissue using HDGF Polyclonal antibody (11344-1-AP)
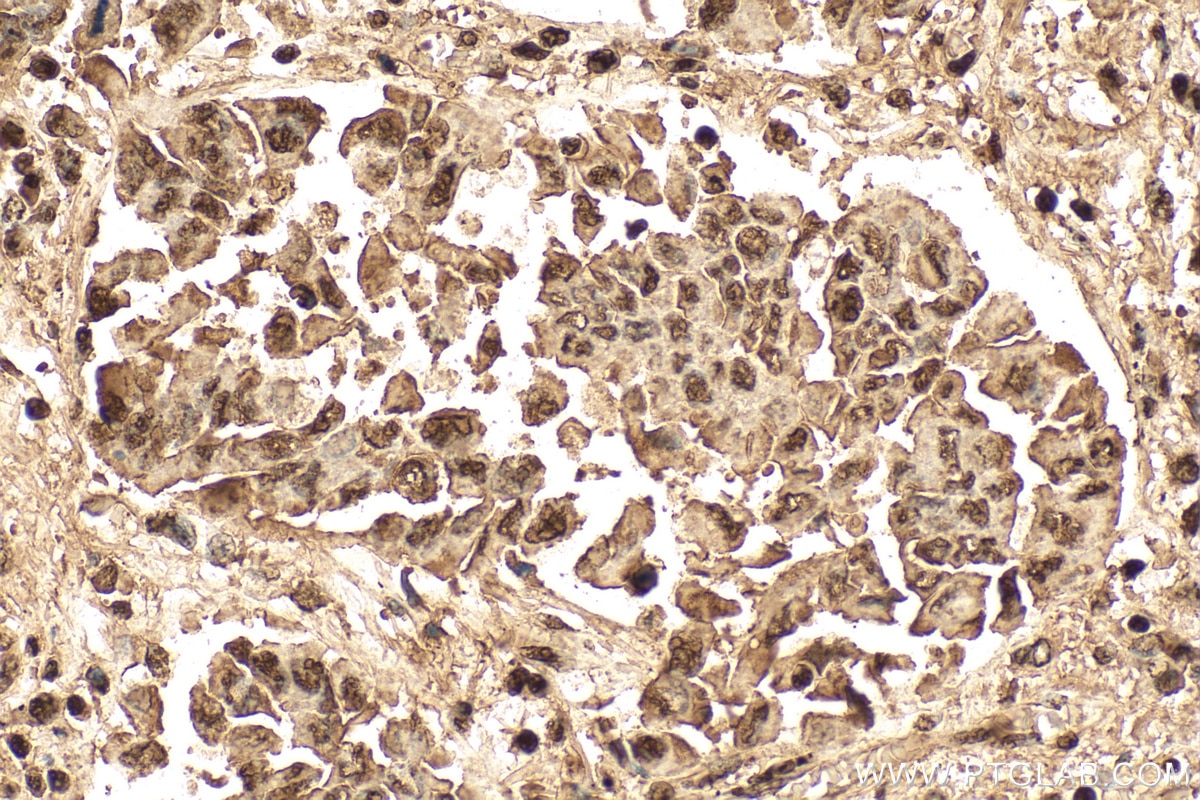
Immunohistochemistry (IHC) staining of human lung cancer tissue using HDGF Polyclonal antibody (11344-1-AP)

Tested Applications
| Positive WB detected in | HepG2 cells, HEK-293T cells, Hela cells |
| Positive IP detected in | HepG2 cells |
| Positive IHC detected in | human colon cancer tissue, human liver cancer tissue, human lung cancer tissue, human ovary tumor tissue Note: suggested antigen retrieval with TE buffer pH 9.0; (*) Alternatively, antigen retrieval may be performed with citrate buffer pH 6.0 |
| Positive IF/ICC detected in | HEK-293 cells |
Recommended dilution
| Application | Dilution |
|---|---|
| Western Blot (WB) | WB : 1:5000-1:50000 |
| Immunoprecipitation (IP) | IP : 0.5-4.0 ug for 1.0-3.0 mg of total protein lysate |
| Immunohistochemistry (IHC) | IHC : 1:200-1:800 |
| Immunofluorescence (IF)/ICC | IF/ICC : 1:50-1:500 |
| It is recommended that this reagent should be titrated in each testing system to obtain optimal results. | |
| Sample-dependent, Check data in validation data gallery. | |
Published Applications
| KD/KO | See 4 publications below |
| WB | See 18 publications below |
| IHC | See 9 publications below |
| IF | See 6 publications below |
| IP | See 5 publications below |
| CoIP | See 2 publications below |
| ChIP | See 2 publications below |
Product Information
11344-1-AP targets HDGF in WB, IHC, IF/ICC, IP, CoIP, ChIP, ELISA applications and shows reactivity with human samples.
| Tested Reactivity | human |
| Cited Reactivity | human, mouse |
| Host / Isotype | Rabbit / IgG |
| Class | Polyclonal |
| Type | Antibody |
| Immunogen |
CatNo: Ag1893 Product name: Recombinant human HDGF protein Source: e coli.-derived, PGEX-4T Tag: GST Domain: 1-240 aa of BC018991 Sequence: MSRSNRQKEYKCGDLVFAKMKGYPHWPARIDEMPEAAVKSTANKYQVFFFGTHETAFLGPKDLFPYEESKEKFGKPNKRKGFSEGLWEIENNPTVKASGYQSSQKKSCVEEPEPEPEAAEGDGDKKGNAEGSSDEEGKLVIDEPAKEKNEKGALKRRAGDLLEDSPKRPKEAENPEGEEKEAATLEVERPLPMEVEKNSTPSEPGSGRGPPQEEEEEEDEEEEATKEDAEAPGIRDHESL Predict reactive species |
| Full Name | hepatoma-derived growth factor (high-mobility group protein 1-like) |
| Calculated Molecular Weight | 26 kDa |
| Observed Molecular Weight | 40-45 kDa |
| GenBank Accession Number | BC018991 |
| Gene Symbol | HDGF |
| Gene ID (NCBI) | 3068 |
| RRID | AB_2232950 |
| Conjugate | Unconjugated |
| Form | Liquid |
| Purification Method | Antigen affinity purification |
| UNIPROT ID | P51858 |
| Storage Buffer | PBS with 0.02% sodium azide and 50% glycerol, pH 7.3. |
| Storage Conditions | Store at -20°C. Stable for one year after shipment. Aliquoting is unnecessary for -20oC storage. 20ul sizes contain 0.1% BSA. |
Background Information
HDGF, also named as HMG1L2, belongs to the HDGF family. HDGF is a mitogen for many cell types with nuclear localization necessary for its mitogenic activity. HDGF has also been identified as an important prognostic marker in pathologic cell growth, as it is overexpressed in a number of cancers with expression linked to a poor outcome in lung, esophageal, pancreatic and hepatic cancer.HDGF is highly expressed in human NSCLC tissues, predicting worse prognosis in resected NSCLCs. It might be useful molecular biomarker for predicting the prognosis of resected NSCLCs.
Protocols
| Product Specific Protocols | |
|---|---|
| IF protocol for HDGF antibody 11344-1-AP | Download protocol |
| IHC protocol for HDGF antibody 11344-1-AP | Download protocol |
| IP protocol for HDGF antibody 11344-1-AP | Download protocol |
| WB protocol for HDGF antibody 11344-1-AP | Download protocol |
| Standard Protocols | |
|---|---|
| Click here to view our Standard Protocols |
Publications
| Species | Application | Title |
|---|---|---|
J Hazard Mater Proteomic analysis of cell proliferation in a human hepatic cell line (HL-7702) induced by perfluorooctane sulfonate using iTRAQ. | ||
Biomaterials Gint4.T-siHDGF chimera-capped mesoporous silica nanoparticles encapsulating temozolomide for synergistic glioblastoma therapy | ||
Mol Oncol Role of hepatoma-derived growth factor in promoting de novo lipogenesis and tumorigenesis in hepatocellular carcinoma.
| ||
Front Cell Dev Biol NAP1L1 Functions as a Tumor Promoter via Recruiting Hepatoma-Derived Growth Factor/c-Jun Signal in Hepatocellular Carcinoma. | ||
Eur J Cancer Identification of glia maturation factor beta as an independent prognostic predictor for serous ovarian cancer. | ||
Hum Cell LncRNA SNHG3 promotes cell proliferation and invasion through the miR-384/hepatoma-derived growth factor axis in breast cancer.
|